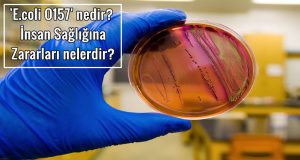
'E.coli O157' nedir? İnsan Sağlığına Zararları nelerdir?

Cumhurbaşkanı Erdoğan’ın, ekonomi yönetimine yönelik eleştirilerini AK Parti’nin son MYK toplantısında da sürdürdüğü bildirildi.
Bazı yerel kaynakların haberine göre Erdoğan, geçtiğimiz günlerde ekonomi yönetimine açıktan yaptığı eleştirileri, AK Parti’nin son Merkez Yürütme Kurulu (MYK)
toplantısında da sürdürdü. Erdoğan’ın tepkisini Başbakan Binali Yıldırım yumuşatmaya çalıştı.
Özellikle faizlerin düşürülmemesiyle ilgili görüşlerini yinelediği belirtilen Erdoğan’ın bu konuda uzun süreden beri yaptığı uyarıların dikkate alınmadığını söyledi. Erdoğan daha önce yapılan toplantılardan örnek vererek, özetle şunları söyledi:
Bu nasıl tek adamlık
“Yurtdışına gitmeden önce faizlerle ilgili bir toplantı yaptık. Düşürülmesinden bahsettik. Nurettin Canikli ve Nihat Zeybekci de oradaydı. Sonra ben yurt dışındayken, Merkez Bankası faiz artırdı. Böyle bir şey olabilir mi? Bağımsızmış… İyi de onların aldığı kararın bedelini biz ödüyoruz. Bir de tek adamlık derler, bu nasıl tek adamlıksa, karar alıyoruz uygulamıyorlar. Benim arkamdan iş çevirdiler. Ekonomi konusunda bazı arkadaşlarımızın açıklamaları çok yanlış. Ekonomik göstergelere bakıyorsunuz en az 50 gösterge olumlu yönde gelişiyor, ama onlar sıkıntılı olan bir iki başlık üzerine konuşuyorlar. Bu büyük terbiyesizlik. Ben sürekli faizlerin aşağı çekilmesi konusunda uyarıyorum. Toplantılarda tamam diyorlar, ama aksi yönde faiz düzenlemesi yapıyorlar. Böyle saygısızlık olur mu?”
Binali Yıldırım, “Ekonomiyle ilgili tüm gösterge ve öneriler kendi aramızda yapılan toplantılarda her yönüyle değerlendiriliyor” diyerek araya girince Erdoğan, “Sadece kendi aramızdaki toplantılarda değil ki, çıkıp kamuoyu önünde de paylaşıyorlar. Görmedik mi geçen gün yapılan toplantılardaki konuşmaları” sözleriyle tepkisini sürdürdü. Erdoğan, ilk kez MYK toplantısında ekonomi yönetimi için bu kadar sert değerlendirmeler yaparken, isim kullanmadı.
Toplantıda et fiyatlarının aşağı çekilememesi de ayrı bir tartışma konusu oldu. Erdoğan, önündeki verilere bakarak, “Et fiyatlarında istenilen düşme sağlanamadı. Bakıyorum, kıyma iki lira artmış” değerlendirmesi yaptı. Erdoğan, Gıda, Tarım ve Hayvancılık Bakanlığı’nın daha fazla inisiyatif olmasını istedi ve “Ne gerekiyorsa yapsınlar” dedi. Bazı MYK üyeleri, ithalatla ilgili sınırlandırmanın belirli sürelerle kaldırılabileceği ve böylece et fiyatlarının aşağı çekilebileceğini söylediler. Hükümetin, özel sektöre belli sürelerle et ithalatına izin verilerek, fiyatların aşağı çekilmesi yönünde karar alabileceği ifade edildi.
Et kaçakçılığı
Toplantıda, et fiyatlarının yüksek olması nedeniyle özellikle Gürcistan gibi ülkelerden kaçak et getirildiğini dile getiren MYK üyeleri oldu. Bir üye, “Vücutlarına et sarıp getiriyorlarmış. Orada 5 liraya aldıkları eti 40 liraya satıyorlarmış” diye anlatınca, Erdoğan, “Bu nasıl olur ya bu mümkün mü?” dedi. Erdoğan’a konuyla ilgili olarak Gümrük Bakanının daha önce yaptığı açıklama dizüstü bilgisayarından gösterildi. Erdoğan, açıklamalara ve habere şaşırarak, “Bu nasıl iş? O kadarcık etle ne yapabilirler” tepkisini gösterdi.
İLGİLİ HABER
Et ve Süt Kurumu’ndan hastalıklı etlerle ilgili açıklama

Bosna Hersek’ten ithal edilen etlerde hastalık çıkmasının haber olmasından sonra açıklama yapan Et ve Süt Kurumu, imha işleminin gerçekleştiğini ve söz konusu etlerin asla piyasaya sürülmediğini savundu.
Gıda, Tarım ve Hayvancılık Bakanlığı aracılığı ile Bosna Hersek’ten ithal edilen 20 ton sığır karkas etinde insan sağlığına zararlı ‘E.coli O157’ hastalığı olduğu ortaya çıktı ve bu etlerin laboratuvar incelemesinin sonuçları beklenmeden piyasaya sürüldüğü iddia edildi.
Oda TV’nin haberinden sonra açıklama yapan ESK ise etlerin piyasaya sürülüp vatandaşlara yedirildiği iddiasının asılsız olduğunu savundu. Açıklamada özetle şöyle denildi:
“İthal edilen etlerin gerekli analiz ve kontrol işlemleri, Veteriner Sınır Kontrol Noktası tarafından yapılmaktadır. Yapılan bu kontrollerde Bosna Hersek’ten getirilen etlerin sadece bir partisinde sağlık sorunu olduğu tespit edilmiştir. Bu etler, analiz sonuçları çıkana kadar 24.08.2017 tarihinde depolarımızda muhafaza altına alınmıştır.
Bu partideki etler, iddia edildiği gibi piyasaya sürülmemiş olup depolarımızda muhafaza altında tutulmuştur. Analiz sonuçlarının olumsuz çıkması üzerine imha işlemlerine, Gıda Ve Yemin Resmi Kontrolüne Dair Yönetmeliğin 20. maddesine göre 05.01.2018 tarihi itibarı ile Erzincan Kombinamız rendering tesislerinde başlanılmıştır.
Kurumumuzun piyasaya sağlıksız et sunması asla söz konusu değildir. Tüm ithalat faaliyetlerinde, işlemlerin sağlık ve teknik kurallara uygunluğu konusunda büyük hassasiyet gösterilmektedir.”
Bosna Hersek’ten Türkiye’ye getirilen etlerde hastalık çıktı
Türkiye’nin, Gıda, Tarım ve Hayvancılık Bakanlığı aracılığı ile Bosna Hersek’ten ithal ettiği 20 ton sığır karkas etinde insan sağlığına zararlı ‘E.coli O157’ hastalığı olduğu ortaya çıktı. Etlerin, laboratuvar incelemesinin sonuçları beklenmeden piyasaya sürüldüğü iddia edildi.
Sizi uyarmıştık, “ 250 bin müslümanı katleden Sırplardan et almak Haramdır” diye.
Bosna’dan ithal edilen 20 ton et hastalıklı çıktı.
Bakan Fakıbaba, ithal eti “Siz yiyebiliyor musunuz” sorusuna “Tabii ki. Vatandaşa yedirdiğim eti ben de yiyorum.” Demişti.
Hesabını kim verecek?? pic.twitter.com/kuSjNoxGrk
— Tacettin BAYIR (@tacettinbayir) 23 Ocak 2018
Hastalığın tespit edilmesiyle birlikte analizi yapan laboratuvar tarafından, Et ve Süt Kurumu Genel Müdürlüğü uyarıldı. Kurum, bunun üzerine İstanbul Depo Müdürlüğü’ne, Sakarya Et Kombinası Müdürlüğü’ne, Sincan Et Kombinası Müdürlüğü’ne ve Diyarbakır Et Kombinası Müdürlüğü’ne, ‘Analizi uygun çıkmayan emtialar’ başlığı altında bir yazı gönderdi.
Bosna Hersek'ten ithal edilen ve analiz sonucu beklenmeden piyasaya sürülen 20 ton karkas ette insan sağlığına zararlı hastalık olduğu tespit ediliyor. Et ve Süt Kurumu piyasaya sürülen etlerin imhasına 5 ay sonra karar veriyor. Halkın sağlığıyla oynamak suçtur!
— Orhan SARIBAL (@orhansaribalchp) January 23, 2018
‘TÜKETİME UYGUN DEĞİLDİR’
Yazıda, Bakanlar Kurulu kararıyla MUJANOVİCİ firmasından alınan etler hatırlatılarak, “Bu ithalat sözleşmesi kapsamında ülkemize giriş yapan tırlardan alınan numunelerde E. Coli O157 pozitif çıktığı ve insan gıdası olarak tüketimin uygun bulunmadığı başkanlığımıza bildirilmiştir” ifadeleri yer aldı.
İMHASI İSTENDİ
Yazının devamında ise etlerin imha edilmesi istendi. Türkiye Et ve Süt Kurumu Genel Müdürlüğü’nden gönderilen yazının son paragrafı şöyle:
“Söz konusu uygunsuz emtiaların, deponuzun bağlı olduğu belediyeye ait imkanlar dahilinde imhası, imkan bulunmayan durumlar için ise Erzincan Et Kombinası rendering tesislerinde imhası için gerekli hazırlıkların yapılması, imha takviminin belirlenmesi ve tarafımızca imha komisyonu oluşturulması için yapılan programın bakanlığımıza bildirilmesi hususunda gereğini rica ederim.”
İMHA YAZISI 5 AY SONRA YAZILDI
İddiaya göre, hastalıklı etler, analiz sonuçları beklenmeden iç piyasaya sürüldü. 29 Ağustos’ta hastalık tespit edilmesine karşın imha yazısı Et ve Süt Kurumu Genel Müdürlüğü Alım ve Üretim Dairesi Başkanı Mustafa Sami Cüceloğlu imzasıyla 5 ay sonra, 5 Ocak 2018’te yazıldı.
‘E.coli O157’ nedir? İnsan Sağlığına Zararları nelerdir?
‘E.coli O157’ nedir? İnsan Sağlığına Zararları Escherichia coli Genelde E. coli kısaltması ile veya koli basili olarak bilinen Escherichia coli (okunuşu Eşerihiya koli), memeli hayvanların kalın bağırsağında yaşayan bakteri türlerinden biridir. Normalde bağırsakta yaşadığı için, E. coli ‘nin çevresel sularda varlığı dışkı kirlenmesinin bir belirtisidir. E. coli, pediyatrist ve bakteriyolog …
Twitter | Facebook | Pinterest | Akademi Portal YouTube